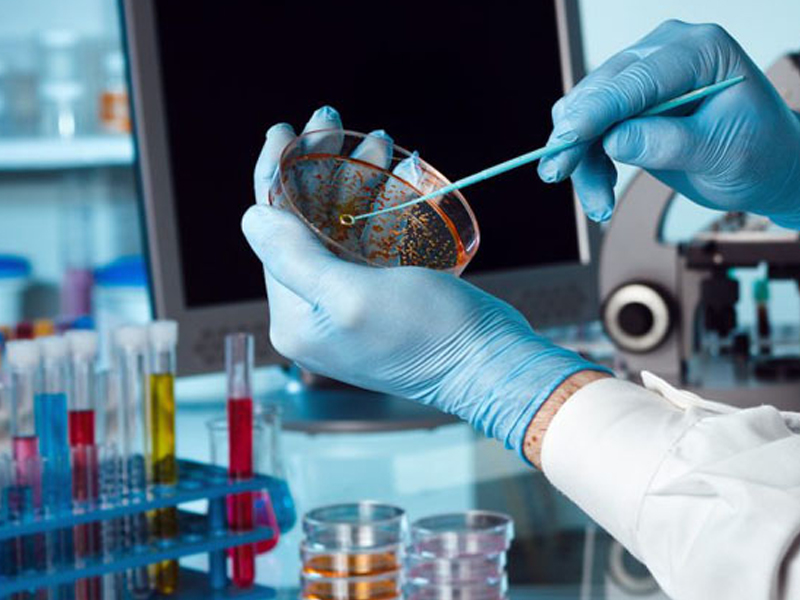
Ruajtja e Qelizave Staminale

Ruajtja e Qelizave Staminale
QELIZAT STAMINALE JANE QELIZA UNIKE, PASI ATO KANË AFTËSINË PËR TË GJENERUAR QELIZA TË REJA TË POTHUAJSE ÇDO LLOJI.
Qelizat burimore fillojnë si qeliza të paspecifikuara por duke pasur sinjalet e duhura kimike dhe gjenetike mund të ndahen për të formuar qeliza më të specializuara me madhësi, formë dhe funksion të ndryshëm, duke marre formen e qelizave shumë të specializuara.
Këto më pas mund të shërbejnë si një sistem riparimi dhe mirëmbajtjeje për qelizat e tjera të trupit, gjakut dhe sistemit imunitar duke u shumëzuar dhe shndërruar në qelizat e kockave, gjakut, indeve dhe organeve kur u kërkohet. Në Smart Cells ne ruajmë qelizat burimore që gjenden në gjakun dhe indin e kordonit të kërthizës. Këto qeliza potenciale gjejnë rrugen e tyre drejt qelizave dhe indeve të dëmtuara në trup dhe fillojnë t'i zëvendësojnë ato.
Për çfarë përdoren qelizat staminale të gjakut të kordonit?
TRANSPLANT
Një transplant i qelizave burimore të gjakut të kordonit mund të përdoret për të zëvendësuar qelizat e sëmura me qeliza të reja të shëndetshme dhe për të rindërtuar sistemin e gjakut dhe imunitetin e një individi. Kohët e fundit, qelizat burimore të gjakut të kordonit kanë treguar se janë në gjendje të formojnë inde të tjera në trup, siç janë qelizat nervore dhe kockore.
POTENCIAL
Qelizat staminale të gjakut të kordonit kanë potencial të konsiderueshëm si një ilaçi rigjenerues. Hulumtimet kanë treguar që këto qeliza janë të afta të zhvillohen në një sërë llojesh qelizash si qelizat nervore, kockore, të lëkurës, zemrës dhe mëlçisë. Kohët e fundit është zbuluar që kanë aftësi të stimulojnë sistemet e rigjenerimit të trupit.
E ARDHMJA
Këto zhvillime emocionuese janë përkthyer tashmë në trajtimin e hershëm klinik të sëmundjes ishemike të zemrës dhe disa gjendje neurologjike. E ardhmja e mjekësisë rigjeneruese duket shumë premtuese dhe gjaku i kordonit ka të ngjarë të luajë një rol kryesor në këtë përparim, në aftësinë tonë për të trajtuar sëmundjet e njeriut.
Kompania SmartCell thotë:
BANKA E GJAKUT TË KORDONIT UMBELIKAL ME KOMPANINË LIDERE TË BRITANISË NË QELIZAT STAMINALE
Në Smart Cells nuk kemi problem të pranojmë që nuk kemi ruajtur më shumë mostra, nuk kemi fituar akreditime ose licenca të panevojshme dhe nuk mund të jemi gjithmonë zgjedhja e parë për çdo klient.
Sidoqoftë, ju po merrni një vendim pionier për të ruajtur qelizat staminale të foshnjës tuaj dhe për të siguruar potencialisht mirëqenien e tyre. Për këtë arsye ne jemi krenarë që jemi kompania e parë në Mbretërinë e Bashkuar që ofron këtë shërbim. Fokusi ynë jeni ju, klienti, dhe ne jemi e vetmja kompani që ju sigurojmë një tabelë krahasimi që nuk favorizon vetëm veten tonë.
Ne nuk kemi nevojë për zbukurime ose fraza të zbukuruara. Ne kemi një pamje unike të krahasimeve dhe mendojmë se është më mirë të jemi të hapur dhe të sinqertë në lidhje me informacionin që ju ofrojmë.

